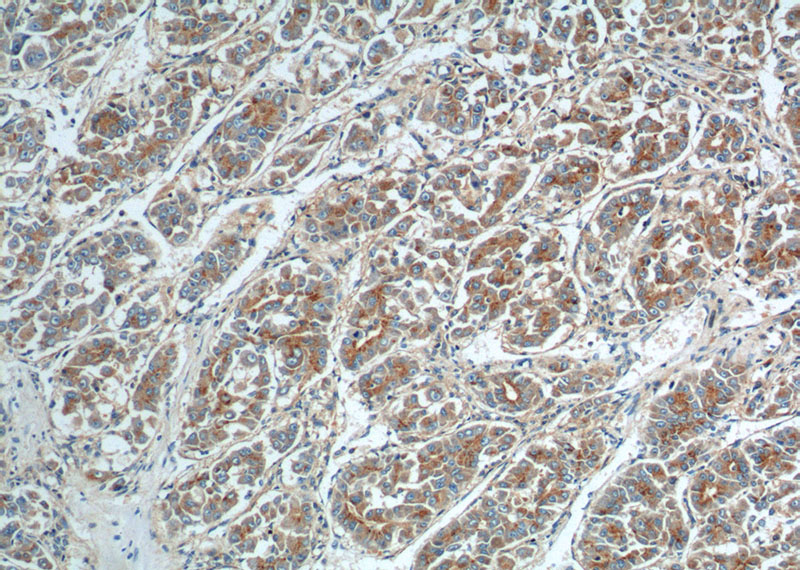
Immunohistochemistry of paraffin-embedded human liver cancer tissue slide using Catalog No:108055(ANGPTL1 Antibody) at dilution of 1:50 (under 10x lens).
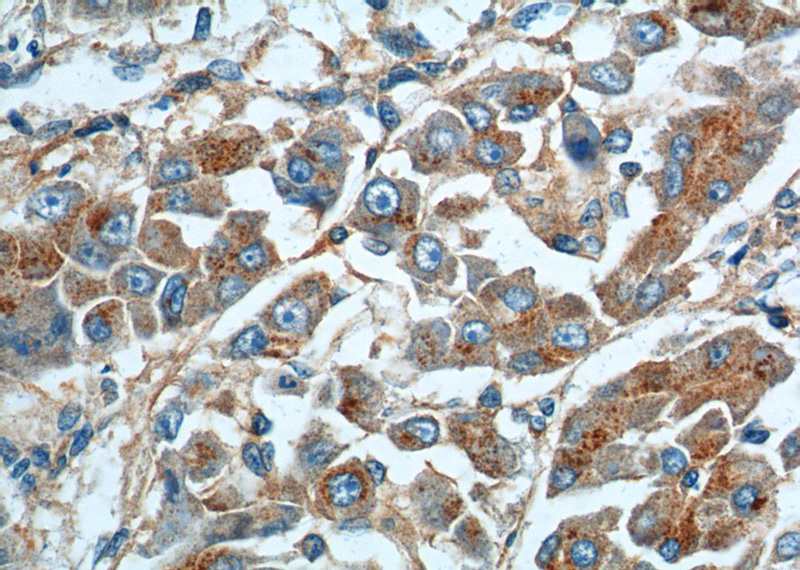
Immunohistochemistry of paraffin-embedded human liver cancer tissue slide using Catalog No:108055(ANGPTL1 Antibody) at dilution of 1:50 (under 40x lens).

-
Product Name
ANGPTL1 antibody
- Documents
-
Description
ANGPTL1 Rabbit Polyclonal antibody. Positive WB detected in HepG2 cells, BxPC-3 cells, HEK-293 cells, HeLa cells, human heart tissue. Positive IHC detected in human liver cancer tissue, human ovary tumor tissue. Observed molecular weight by Western-blot: 55 kDa
-
Tested applications
ELISA, WB, IHC
-
Species reactivity
Human,Mouse,Rat; other species not tested.
-
Alternative names
ANG 3 antibody; ANG3 antibody; Angiopoietin 3 antibody; angiopoietin like 1 antibody; Angiopoietin like protein 1 antibody; Angiopoietin related protein 1 antibody; ANGPT3 antibody; ANGPTL1 antibody; AngY antibody; ARP1 antibody; dJ595C2.2 antibody; KIAA0351 antibody; UNQ162 antibody; UNQ162/PRO188 antibody
-
Isotype
Rabbit IgG
-
Preparation
This antibody was obtained by immunization of ANGPTL1 recombinant protein (Accession Number: NM_001376763). Purification method: Antigen affinity purified.
-
Clonality
Polyclonal
-
Formulation
PBS with 0.02% sodium azide and 50% glycerol pH 7.3.
-
Storage instructions
Store at -20℃. DO NOT ALIQUOT
-
Applications
Recommended Dilution:
WB: 1:200-1:2000
IHC: 1:20-1:200
-
Validations

HepG2 cells were subjected to SDS PAGE followed by western blot with Catalog No:108055(ANGPTL1 antibody) at dilution of 1:300
Immunohistochemistry of paraffin-embedded human liver cancer tissue slide using Catalog No:108055(ANGPTL1 Antibody) at dilution of 1:50 (under 10x lens).
Immunohistochemistry of paraffin-embedded human liver cancer tissue slide using Catalog No:108055(ANGPTL1 Antibody) at dilution of 1:50 (under 40x lens).
-
Background
Angiopoietin-like protein (Angptl) 1, also known as angiopoietin-related protein 1 (ARP1) and angioarrestin, belongs to the angiopoietin-like family of proteins (Angptls). It is a secretory glycoprotein that shares two basic structural motifs with the angiopoietin family: an N-terminal coiled-coil domain and a C-terminal fibrinogen-like domain. Angptl1 is widely expressed in adult tissues with mRNA levels highest in highly vascularized tissues. It is related to development of the connective tissue and cartilage. This protein was found to be a secretory protein that does not act as an endothelial cell mitogen in vitro.
-
References
- Akhter S, Rahman MM, Lee HS, Kim HJ, Hong ST. Dynamic roles of angiopoietin-like proteins 1, 2, 3, 4, 6 and 7 in the survival and enhancement of ex vivo expansion of bone-marrow hematopoietic stem cells. Protein & cell. 4(3):220-30. 2013.
Related Products / Services
Please note: All products are "FOR RESEARCH USE ONLY AND ARE NOT INTENDED FOR DIAGNOSTIC OR THERAPEUTIC USE"
